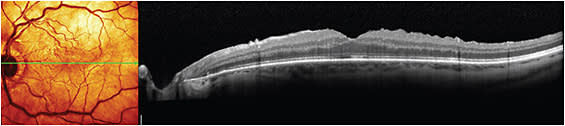

Treating retinal disease prior to cataract surgery
Failure to identify, attend to the pathology could affect your patient’s visual outcome.
By Karen Blum, Contributing Editor
To make sure your patients see well after cataract surgery, you must identify whether the patient also has retinal disease prior to the procedure. Failure to address coexisting retinal disease could cause any gain from cataract surgery to be eclipsed by the progression of retinal pathology and will lead to more severe outcomes or a delay in visual outcomes, says Damien Goldberg, MD, a partner in Wolstan & Goldberg Eye Associates in Torrance, Calif. Also, you could be liable for poor outcomes because of unidentified retinal pathology prior to surgery, he says. “Patients will be disappointed that their surgery doesn’t look like it worked, and their vision will potentially be persistently hindered, or held back.”

Left eye with severe vitreomacular traction syndrome.
IMAGE COURTESY STEVEN G. SAFRAN, MD

Right eye with lamellar macular hole.
IMAGE COURTESY STEVEN G. SAFRAN, MD
Retinal pathology prevalence
John Sheppard, MD, president of Virginia Eye Consultants in Norfolk, says up to 15% of his cataract surgery patients have some retinal pathology, the most common of which is diabetic retinopathy (DR). Other common retinal conditions co-occurring with cataract include age-related macular degeneration (AMD), epiretinal membrane (ERM) or macular pucker, retinal vein occlusion, lattice degeneration, retinal detachment or retinal hemorrhages.
While cataract surgeries can cause some retinal diseases to progress, a 2009 study has shown that’s not the case with AMD.1 The natural rate of progression in those with dry AMD to wet AMD is about 5% to 10% per year, says Walter Stark, MD, chief of the Division of Cornea, Cataract and External Eye Diseases at the Johns Hopkins Wilmer Eye Institute in Baltimore.
“All of these cases should be followed by someone who is familiar with macular degeneration, or has the ability to analyze these cases.” This could be the general ophthalmologist who’s doing the cataract surgery or an expert in DR or AMD. An unpublished study that Dr. Stark coauthored indicates that patients with DR and ERM can worsen after cataract surgery even if nonsteroidal anti-inflammatory drugs are used pre- and postoperatively.
“You can have a wonderful-looking anterior segment, a wonderful-looking surgical result, and an unhappy patient,” adds Dr. Sheppard.
Identify the disease
To avoid frustrations, do everything you can to identify retinal disease ahead of cataract surgery, say those interviewed. These include a thorough eye exam and medical history. While taking a medical history, look for the presence of autoimmune conditions, especially those that require powerful medications or disease-modifying antirheumatic drugs (DMARDs); diabetes (especially if uncontrolled); a history of trauma; and a family history of macular degeneration, say those interviewed. Also, to help with diagnosis, those in Dr. Goldberg’s practice use an OCT machine, fundus camera, nonvitreotic camera and fluorescein angiography, if necessary. “We look at everything from A to Z, starting in the front with the tear film,” he says.
It’s important to have a good relationship with a local retinal consultant as well, Dr. Sheppard says. “Whenever there’s a doubt, we’ll have our retina doctor take a look, especially if there are symptoms, Amsler grid changes, unexplained visual loss, diabetes mellitus, OCT findings, or evidence of maculopathy on examination.” Dr. Sheppard has found retinal consultants easy to work with and says they’re often willing to share their expertise.
Preparing for surgery
Along with identifying the disease, you must make efforts to halt the disease’s progression. “If there’s anything active that’s potentially exacerbated by the cataract surgery, you really have to be on top of it,” says Dr. Sheppard.
Both chemical (increased level of interleukin, VEGF and other inflammatory factors) and mechanical factors (vitreomacular interface and the movement of the vitreous due to intraocular volume loss after removing lens material) play a role in the retinal pathology progression after cataract surgery, says Sam Farah, MD. “The most important factor in preparing these types of patients for cataract surgery is to have the retinal pathology well treated and under control prior to surgery and to control postoperative inflammation,” says Dr. Farah, a retina specialist in New York City and an assistant professor of ophthalmology and visual sciences at Albert Einstein College of Medicine.
Ophthalmologists can try various things prior to surgery to reduce a patient’s risk of retinal disease progression, says Dr. Farah.2 Topical nonsteroidal anti-inflammatory drops plus steroid drops may prevent cystoid macular edema development and macular edema progression in some patients who have DR or retinal vein occlusion, he says. Also, perioperative use of anti-VEGF medicines can reduce postsurgical retinal edema and the progression of diabetic retinopathy, Dr. Farah says. However, these medications should be used cautiously in patients with proliferative DR as rapid regression of neovascularization and traction retinal detachment could ensue.

Epiretinal membrane with macula thickening prior to surgery.
IMAGE COURTESY STEVEN G. SAFRAN, MD
Same patient after combined PPV/membrane peel/phacoemulsification with PCIOL.
IMAGE COURTESY STEVEN G. SAFRAN, MD
In addition, nutritional supplements as recommended in the AREDS2 study can benefit patients with AMD who are at risk for progression.3 The vitamins decrease the chance of progression by about 10% to 20%, Dr. Stark says, citing the original AREDS study: “I recommend them when a patient has intermediate-sized drusen, especially with pigment clumping, either pre- or postoperatively.”4
Discuss all possibilities with your patients, and make sure they are well informed about their choices and potential complications, Dr. Goldberg says. In addition, make every effort to appropriately manage patients’ expectations, Dr. Sheppard says: “If they have a retinal problem and you never warned them, you’ll never win.”
Also, Dr. Sheppard recommends leaving 10 to 15 more minutes on the surgery schedule than a typical cataract surgery to allow time to manage potential complications and reduce stress on the surgeon.
IOL selection
Choosing the correct lens also is key, say those interviewed. For patients with ERM or significant AMD, do not choose a multifocal lens, Dr. Sheppard advises. “Without ideal macular function, not only is the potential benefit of the multifocal lens lost but the potential for a disgruntled, frustrated and really dysfunctional postcataract patient is greatly increased.”
While Dr. Goldberg agrees that multifocal IOLS are generally out for these patients, he decides on a case-by-case basis. “I never like to pigeonhole and say none of these patients should ever have this lens,” he says. “I think that does a disservice. It’s a very customized doctor-patient-retinal surgeon case-by-case path.”
In addition, Dr. Goldberg recommends premium lenses. “These are really amazing technologies that can impact our patients’ outcomes and improve their results.” Dr. Goldberg says to consider all types of lenses for patients with mild retinal disease. For patients with moderate to severe disease, he tends to shy away from multifocal but still sees value in an astigmatic toric lens, or an accommodating lens, such as Crystalens (Bausch + Lomb) or Trulign (Bausch + Lomb) to improve patient outcomes. For patients with severe disease, he says a telescopic lens may be helpful. Also, consider IOLs that block ultraviolet (UV) light for patients with AMD, Dr. Farah says.
Consider surgery technique
“Precise surgical planning is essential to avoid [complications],” says Dr. Sheppard. For example, patients with zonular weakness or previous ocular trauma have an increased risk for capsular complications such as rupture. Therefore, consider using a Malyugin ring, iris retractor or device to maintain pupil dilation to avoid capsular complications during surgery, including phenylephrine and ketorolac injection (Omidria, Omeros) and femtosecond laser to assist with incisions. Also, make sure patients are adequately sedated and positioned correctly.
Postsurgery
After surgery, monitor patients closely to make sure there is no induction of progression resulting from the surgery, Dr. Farah says. Use steroids and nonsteroidal medications more intensively, and for a longer period of time, Dr. Sheppard advises. This generally extends the standard regimen of twice a day Durezol (difluprednate Ophthalmic Emulsion, Alcon) or loteprednol etabonate (Lotemax Gel, Bausch + Lomb) to six weeks rather than four weeks, and the topical NSAID to at least six weeks, he says. Also, be wary of generic topical nonsteroidals, he says, which require administration four times a day and can cause significant stinging in some patients. Patients who require sustained therapy, like those with ERM, macular edema or DED, can benefit from more advanced formulations such as Ilevro (nepafenac ophthalmic suspension, Alcon) or Prolensa (bromfenac ophthalmic solution, Bausch + Lomb).
And, despite UV filters in IOLs, AMD patients should be advised to wear glasses with UV light protection and hats on sunny days, say those interviewed.
In patients with peripheral retinal holes or lattice degeneration, some doctors recommend prophylactic laser therapy to seal these areas, Dr. Stark says. “It’s not a hard and fast rule, but it’s a good idea to have people with peripheral retinal pathology followed by a retinal specialist,” he says. He also warns these patients that they are at risk of retinal detachment, and goes over warning signs. “If we see those patients early, after a retinal detachment might start, we’re successful in repairing that over 90% of the time.”
With a good relationship with a retinal specialist, a complete medical history and preoperative exam, and open conversations with your patients on what to expect, you can maximize surgical outcomes and patient satisfaction. OM
Dr. Goldberg is a clinical investigator for Alcon, Bausch + Lomb, and Calhoun, and a consultant for Alcon, Allergan and Calhoun. Dr. Sheppard is a consultant for Allergan, Bausch + Lomb, Alcon and Omeros.
REFERENCES
1. Dong LM, Stark WJ, Jefferys JL, et al. Progression of age-related macular degeneration after cataract surgery. Arch Ophthalmol. 2009;127:1412-1419.
2. Farah SE. The impact of cataract surgery on preexisting retinal disease. EyeNet Magazine (AAO). Sept 2010: 41-43.
3. Age-Related Eye Disease Study 2 Research Group. Lutein + zeaxanthin and omega-3 fatty acids for age-related macular degeneration: the Age-Related Eye Disease Study 2 (AREDS2) randomized clinical trial. JAMA. 2013;309:2005-2015.
4. Age-Related Eye Disease Study Research Group. A randomized, placebo-controlled, clinical trial of high-dose supplementation with vitamins C and E, beta carotene, and zinc for age-related macular degeneration and vision loss. Arch Ophthalmol. 2001;119:1417-1436.








